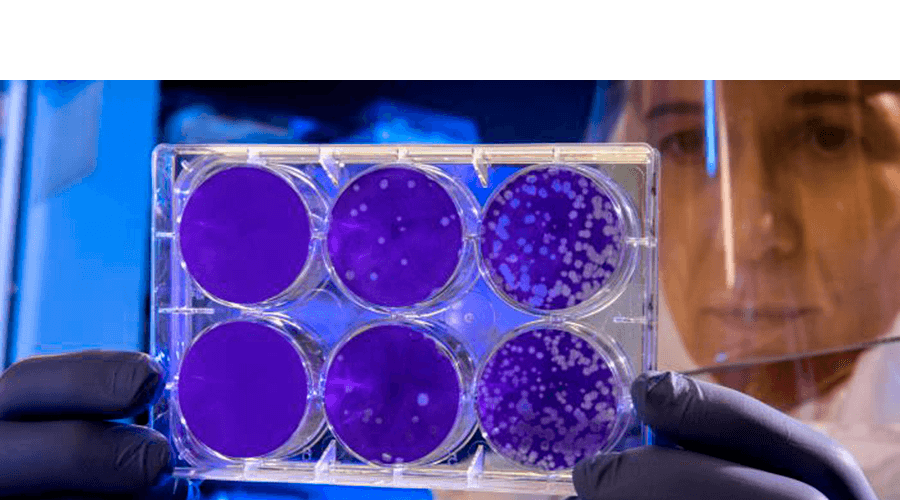
Simpiox Precio España

Simpiox precio españa
Antihelmíntico y microfilaricida. Es eficaz también frente a sarna y piojos.
Llevamos viviendo con él lo que a veces parece una eternidad. Una de las funciones de la FDA es evaluar cuidadosamente los datos científicos de un medicamento para asegurarse de que es seguro y eficaz para un uso determinado. En algunos casos, puede ser muy peligroso utilizar un medicamento para la prevención o el tratamiento del COVID que no haya sido aprobado o que no haya recibido la autorización de uso de emergencia por parte de la FDA. Parece que hay un interés cada vez mayor en el uso de un medicamento llamado ivermectina para la prevención o el tratamiento del COVID en los seres humanos. La ivermectina no ha demostrado ser segura ni eficaz para estas indicaciones. Incluso los niveles de ivermectina para usos humanos aprobados pueden interactuar con otros medicamentos, como los anticoagulantes. Estas dosis tan elevadas pueden ser muy tóxicas para el ser humano.
Durante un examen, el proveedor de atención médica puede utilizar una lupa para buscar piojos. También puede usar una luz especial, llamada luz de Wood, para comprobar si hay liendres. Un proveedor de atención médica puede diagnosticar piojos corporales si encuentra huevos o piojos que se deslizan en las costuras de la ropa o en la ropa de cama. Puedes ver un piojo corporal en la piel si se desliza allí para alimentarse. Aplicar una cantidad excesiva puede irritar y enrojecer la piel.
Puedo conseguir simpiox precio españa visa en línea
Su actividad antiparasitaria ha extendido su uso a animales de compañía como los perros y los gatos. La administración sobre la piel puede causar alopecia y descamación en la zona. La selamectina o la moxidectina son otras lactonas muy utilizadas que suelen emplearse en pipetas y que constituyen una alternativa a la ivermectina para gatos. Debido a la importancia de los órganos a los que afecta, es una parasitosis de gravedad potencialmente mortal. Tanto la cantidad a administrar como la frecuencia de la dosis de ivermectina para gatos son muy variables, pues va a depender del motivo por el que la utilicemos. Es por ello muy importante que, en todos los casos, antes de darle ivermectina al gato consultemos con el veterinario, incluso aunque ya se la hayamos suministrado con anterioridad. Por supuesto, haber utilizado la ivermectina en otros animales no implica que vaya a tener el mismo efecto en el gato. A continuación, examinaremos las posibles reacciones adversas.
| Embalaje | Por pastilla | Precio total | Orden |
|---|---|---|---|
| 30 Pastillas | $1.40 |
$41.99
|
Añadir al carrito |
| 60 Pastillas | $1.12 |
$66.99
|
Añadir al carrito |
| 90 Pastillas | $1.01 |
$90.99
|
Añadir al carrito |
| 120 Pastillas | $0.91 |
$108.99
|
Añadir al carrito |
| 180 Pastillas | $0.82 |
$146.99
|
Añadir al carrito |
Para ejemplo, hormona antidiurética utilizada para tratar la diabetes insípida y hormonas utilizadas para El tratamiento de la infertilidad se puede administrar por esta vía. Esta ruta puede ser otra forma de evitar destrucción de un fármaco por enzimas hepáticas o ácido del estómago y enzimas digestivas. Factores que afectan la absorción a través de las membranas mucosas, similares a las consideradas bajo administración. La administración tópica a la epidermis de la piel se usa generalmente para medicamentos destinados para tener un efecto local. Esta ruta es de especial relevancia para los podólogos y se puede utilizar para tratar una infección local u otras afecciones.
Simpiox precio españa pago online con paypal
Figura inyecciones. Es muy probable que el nivel de actividad mostrado en el gráfico hasta finales se debe a las administraciones intravenosas asociadas con los procedimientos de medicina nuclear. Como anécdota, se sabe que, por de lo contrario, pero es probable que tales prácticas no estuvieran dentro de la legislación vigente en ese momento. Los cambios en la legislación permitieron la adopción de nuevos roles por los radiógrafos y, durante la destacan las administraciones intravenosas de agentes de contraste para las investigaciones del tracto urinario. Por el temprano-medio el papel de los radiógrafos en la administración de medicamentos. Esto fue apoyado por profesionales literatura corporal, que se sigue produciendo en la actualidad (Sociedad de Radiógrafos, y Sociedad de Radiógrafos, Junto a la demanda clínica de radiógrafos para administrar medicamentos, vino la demanda para que los programas de educación y formación universitarios y hospitalarios cumplan con la formación necesitar.
De iones, pero también puede deberse a las partes hidrófobas de la molécula. Los agentes de contraste no iónicos más nuevos tienen estructuras mediante las cuales una cadena lateral hidrófila protege el anillo de benceno simpiox precio españa esto hace que la molécula sea menos tóxica. Se enumeran las reacciones adversas a los agentes de contraste de yodo, calificadas como leves, moderadas y graves. sin tratamiento; Las reacciones adversas moderadas pueden interferir con el examen radiológico, pero generalmente no requieren tratamiento; y las reacciones adversas graves requieren que el examen sea detenido y tratamiento de emergencia. La fibrosis sistémica nefrogénica se ha relacionado con el uso de agentes de contraste de gadolinio.
Lugares para conseguir simpiox precio españa tarjeta de credito online
Actúa dañando la cabeza de la tenia. para que ya no pueda adherirse al interior del intestino. La niclosamida tiene pocos efectos secundarios, pero ha sido reemplazada por praziquantel. El praziquantel es un antihelmíntico muy eficaz, que induce la contracción muscular y la parálisis espástica en trematodos y cestodos aumentando flujos de iones de calcio. Los efectos adversos rara vez tienen importancia clínica.
Puedo ordenar simpiox precio españa legalmente en línea?
El dolor se describe como ardor, dolor punzante o escaldado y puede ser difícil de tratar con analgésicos convencionales. A menudo, una combinación de fisioterapia y tratamiento psicológico junto con Se necesita uno o más de los siguientes enfoques.
Donde puedes conseguir simpiox precio españa con seguro?
Le han recetado celiprolol y después de tomarlo solo durante un A los pocos días se queja de sentirse mareada y como si fuera a desmayarse. ¿Cómo puedo tranquiliza a la Sra.
- ¿Cómo se puede tranquilizar a un niño que parece no querer hablar.
- Para severo eccema refractario a otros tratamientos, la ciclosporina está autorizada para uso oral y tacrolimus tiene licencia para uso tópico.
- Otro ejemplo sería la administración de anestésicos locales y antiinflamatorios.
- Con el advenimiento llegaron nuevos desarrollos en la prescripción para profesionales de la salud.
Los diuréticos tiazídicos actúan inhibiendo el transporte de iones de sodio y cloruro en la zona distal. túbulo contorneado del riñón y, por lo tanto, limitar la reabsorción de agua.
Hay muchas razones por las que la analgesia es deseable. El dolor puede deberse a una enfermedad crónica, una lesión aguda o debido a una cirugía o manipulación. Aunque es poco probable, pero no imposible, que los ivermectina tabletas mexico de la salud administrar anestésicos generales, se incluyen aquí en aras de la integridad y porque es posible que una sobredosis de anestésicos locales pueda causar anestesia. Los podólogos registrados que posean un certificado de competencia pueden administrar anestésicos locales en el curso de su práctica profesional de una lista especificada en el Ley de medicamentos. Los fisioterapeutas y radiólogos pueden administrar anestésicos locales en algunas circunstancias bajo las instrucciones del grupo de pacientes.

La secuencia de bases forma un conjunto de instrucciones o un código para el ensamblaje de aminoácidos en proteínas. Un tramo de ADN que codifica un una proteína particular se conoce como gen. El ADN se empaqueta en el núcleo de las células en el forma condensada de cromosomas. En las células humanas hay espermatozoides y óvulos donde hay La replicación del ADN tiene lugar antes de que una célula se divida y necesita desenrollarse y desenrollarse. separación de las dos hebras. Esto requiere la acción de enzimas.